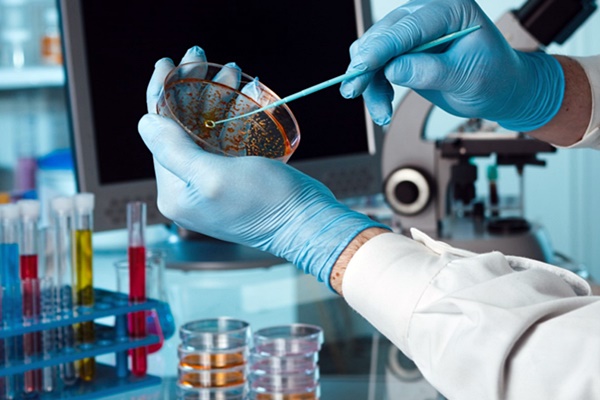

Ponad połowę środków przeznaczonych na walkę z grypą ptaków wydano z naruszeniem prawa, z powodu przewlekłych procedur administracyjnych. Hodowcy zbyt długo czekali na odszkodowania, rzeczoznawcom brakowało doświadczenia, a w systemie szacowania strat były luki.
Najwyższa Izba Kontroli sprawdziła, jak w 5 województwach przeciwdziałano rozprzestrzenianiu się grypy ptaków i zwalczano jej skutki. I choć kontrolerzy stwierdzili nieprawidłowości, to zdaniem Izby często były one usprawiedliwione – skalą zagrożenia i koniecznością szybkiego reagowania w sytuacjach kryzysowych.

Grypa ptaków (HPAI) to niezwykle zaraźliwa choroba, która może powodować śmiertelność sięgającą nawet 100% zainfekowanych osobników. I choć narażone na zachorowania są niemal wszystkie gatunki od domowych po dzikie, najczęściej grypa ptaków występuje u kur i indyków, a okres jej wylęgania waha się od kilku godzin do 2-3 dni. W naszym kraju, który jest czołowym producentem drobiu w Europie (16% całego unijnego drobiu pochodzi z Polski) kluczowe jest więc błyskawiczne podejmowanie działań, które zapobiegną rozprzestrzenianiu się wirusa i zwalczą skutki zachorowań.
Wydatki z naruszeniem prawa
Kontrola NIK wykazała, że od stycznia 2016 r. do września 2018 r. w województwach: lubuskim, wielkopolskim, dolnośląskim, małopolskim i podkarpackim wojewodowie oraz Inspekcja Weterynaryjna podejmowali właściwe działania ograniczające rozprzestrzenianie się zachorowań drobiu na grypę ptaków. Izba ustaliła jednak, że ponad połowa przeznaczonych na ten cel środków była wydawana z naruszeniem prawa. Inspekcja Weterynaryjna naruszała bowiem zasady właściwego gospodarowania środkami finansowymi, zaciągając na walkę z chorobą wielomilionowe zobowiązania, choć nie było tych pieniędzy w jej budżecie. Inspekcja – kierując się nadrzędnym dobrem jakim jest szybkie zwalczenie choroby – zawierała z firmami zewnętrznymi umowy na ubój, utylizację i dezynfekcję, pomimo że nie miała takich uprawnień.

Głównym powodem powstania nieprawidłowości finansowych było to, że powiatowe inspektoraty weterynarii, które mają w sytuacji wystąpienia choroby zakaźnej drobiu najwięcej obowiązków, zbyt długo czekały na pieniądze potrzebne do walki z rozprzestrzenianiem się grypy ptaków.
Zgodnie z przepisami, aby otrzymać takie środki, powiatowi lekarze weterynarii zwracają się do poszczególnych lekarzy wojewódzkich, ci z kolei do wojewodów, a wojewodowie do Ministerstwa Rolnictwa i Rozwoju Wsi. Następnie szef tego resortu składa wniosek do Ministerstwa Finansów o przekazanie pieniędzy z rezerw celowych. Mimo że wojewodowie nie zwlekali z przekazywaniem środków organom Inspekcji Weterynaryjnej, w efekcie tego wydłużonego procesu naruszano zasady dotyczące właściwego dysponowania publicznymi pieniędzmi, a hodowcy po stracie stada musieli czekać kilka miesięcy na wypłatę odszkodowań.
Nieprawidłowości finansowe, dotyczące przypadków w których konieczne było podjęcie natychmiastowych działań w obszarach zapowietrzonych, wystąpiły w siedmiu na 9 kontrolowanych powiatowych inspektoratach weterynarii. Polegały one na tym, że powiatowi lekarze weterynarii zaciągali zobowiązania, mimo że w planie finansowym nie było zabezpieczenia odpowiednich środków. Zlecali też ubój, utylizację czy dezynfekcję, mimo że nie mieli uprawnień do zawierania umów na przeprowadzenie takich działań. Jak ustaliła NIK, z naruszeniem prawa wydano w ten sposób w kontrolowanych województwach 66,6 mln zł, czyli 58% wydatków przeznaczonych tam na walkę z grypą ptaków. Zgodnie z prawem nie dochodzi się jednak odpowiedzialności za naruszenie dyscypliny finansów publicznych, jeśli podjęto działania lub ich zaniechano w celu ograniczenia skutków zdarzenia losowego.
NIK zwraca też uwagę na to, że mimo finansowych nieprawidłowości wojewodowie, choć mają takie uprawnienia, nie skontrolowali czy organy Inspekcji Weterynaryjnej prawidłowo wydawały pieniądze na zwalczanie skutków rozprzestrzeniania się grypy ptaków w 2016 r. i 2017 r., nie zaplanowali też przeprowadzenia takich kontroli w 2018 r. Zdaniem NIK były one nieodzowne ze względu na wysokość środków przeznaczonych na walkę z grypą ptaków oraz duże prawdopodobieństwo wystąpienia nieprawidłowości, spowodowane koniecznością natychmiastowego podejmowania działań w ogniskach choroby oraz w strefach zapowietrzonych i zagrożonych.
Pomysł z Niemiec na procedury
W niektórych państwach Unii Europejskiej funkcjonują rozwiązania, które umożliwiają szybką, a zarazem zgodną z prawem reakcję na wystąpienie epizootii. Na przykład w Republice Federalnej Niemiec utworzono w poszczególnych krajach związkowych tzw. kasy chorych zwierząt, które mają do dyspozycji odpowiednie kadry i przedsiębiorstwa, które zajmują się zabijaniem i utylizacją stad drobiu oraz przeprowadzaniem dezynfekcji. Firmy te podejmują stosowne działania w ciągu doby od zgłoszenia zapotrzebowania przez odpowiedniego lekarza weterynarii. Wszystko to jest finansowane z funduszy poszczególnych krajów związkowych, budżetu federalnego i składek wnoszonych przez hodowców.
Ile wydano na walkę z grypą ptaków?
W 2017 r., kiedy zasięg i rozmiary grypy ptaków w Polsce były największe, na walkę z epizootią w całym kraju wydano w sumie blisko 120 mln zł, przy czym odszkodowania dla hodowców wyniosły 80 mln zł. W skontrolowanych województwach wydatki te odpowiednio wyniosły: 115 mln zł oraz 77,5 mln zł.
Z kontroli NIK wynika, że tylko w niewielkim stopniu źródłem finansowania wydatków przeznaczonych na zwalczanie grypy ptaków były środki pierwotnie przewidziane w planach finansowych poszczególnych powiatowych inspektoratów weterynarii. Zdecydowana większość pochodziła z rezerw celowych. Na przykład w województwie lubuskim, gdzie skala i intensywność epizootii była największa, przewidziano kwotę 192 tys. zł, ale wraz z rozprzestrzenianiem się grypy ptaków wydano tam kolejne 64,5 mln zł z rezerw celowych.
Wydatki na walkę z grypą ptaków w 2017 r. w skontrolowanych województwach (w tym odszkodowania)
- województwo lubuskie – 64,7 mln zł, w tym odszkodowania dla hodowców – 39,1 mln zł;
- województwo wielkopolskie – 34 mln zł, w tym odszkodowania – 25,5 mln zł;
- województwo dolnośląskie – 14,2 mln zł, w tym odszkodowania – 12 mln zł;
- województwo małopolskie – 2,1 mln zł, w tym odszkodowania – 761,7 tys. zł;
- województwo podkarpackie – 50 tys. zł, w tym odszkodowania – 8,2 tys. zł.
Dla hodowców, którzy stracili całe stada w związku z wystąpieniem grypy ptaków najistotniejsza jest kwestia odszkodowań. Za nakazane zabicie m.in. kur, kaczek, gęsi czy indyków, a także za zwierzęta, które padły podczas zabiegów związanych ze zwalczaniem chorób zakaźnych, hodowcom przysługuje odszkodowanie z budżetu państwa. Podobnie za zniszczone produkty pochodzenia zwierzęcego, jaja wylęgowe, pasze oraz sprzęt, które nie mogą być poddane odkażaniu. Odszkodowanie jest wyliczane na podstawie wartości rynkowej zwierząt, produktów czy sprzętu przez powiatowego lekarza weterynarii i dwóch wskazanych przez niego rzeczoznawców.
Źródło: NIK
Czytaj:
https://pharmaexpress.pl/ptasia-grypa-szczegolne-srodki-ostroznosci/